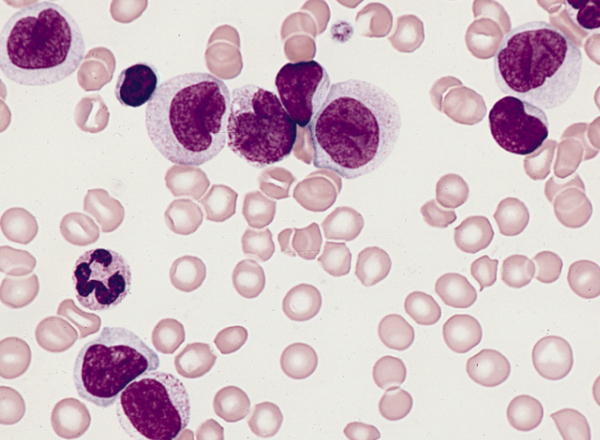
CJASN Podcast Hosts Dr. Tingting Li and Co-authors to Discuss Monocyte Count and CKD Publication

Read the latest news from the Nephrology Division.
CJASN Podcast Hosts Dr. Tingting Li and Co-authors to Discuss Monocyte Count and CKD Publication
Associate Professor of Medicine Tingting Li, Division of Nephrology at WU, and colleagues from the Clinical Epidemiology Center at the VA Saint Louis Health Care System participated in the recently launched CJASN Podcast to discuss their publication Association between Monocyte Count and Risk of Incident CKD and Progression to ESRD. Dr. Li, first author and […]
NephMadness 2017 Champion: Genes in ESKD Disparity
The winner of NephMadness 2017 has been decided. In a 5-4 determination of the AJKD Blog blue ribbon panel, Genes in ESKD Disparity beat CRISPR-Cas9. Over the last four weeks, the educational tournament NephMadness 2017 has played out over the web and social media outlets. The interactive event was a big hit featuring upsets, participation […]
1in9 Kidney Awareness Documentary Visits Division of Nephrology
Analyn Scott swipes through the pictures on her phone, finds the one she is searching for and proudly holds it up for all to see. The picture is of a man and woman in full Dancing with the Stars costumes, frozen mid-step in what appears to be a very energetic dance. “Tell me if that […]
Tarek Alhamad to Serve on KPCOP Executive Committee
Division of Nephrology Assistant Professor of Medicine Tarek Alhamad has been elected to serve a two-year term as a Committee Member-at-Large on the Kidney Pancreas Community of Practice (KPCOP) Executive Committee. Members of the KPCOP Executive Committee advise the American Society of Transplantation (AST) Board of Directors on its goal of promoting research, education, advocacy, […]
APOL1 Gene Variants are Causal Factors of Kidney Disease in African Americans
Professor of Medicine Jeff Miner, PhD, FASN, Division of Nephrology, is co-author of a recent study in Nature Medicine that proves that certain variants of the APOL1 gene cause kidney disease. For years, it has been known that African Americans have a 3-5-fold increased risk of developing chronic kidney disease (CKD) and end-stage renal disease […]
They Call Her “Ms. Tee”
Congratulations to Teana Allen, Secretary II in the Chromalloy Kidney Center, who recently graduated from Ashford University with a Master of Arts in Organizational Management with a specialization in Business Leadership. Teana attributes part of her academic drive to her grandmother. “Before my grandmother passed, she always told me, no matter what, she wanted me […]
Rolling in – Dr. Brennan’s Back
It has been a long road to recovery for Dr. Dan Brennan after his accident on Camelback Mountain in October 2016. When asked how his leg is healing, he slips off his shoe, lifts his pant leg, and pulls off his compression socks to reveal the long purple scar that runs from his right calf […]
Andrew Malone Interviews for World Kidney Day on Fox 2 Now
Dr. Andrew Malone, Washington University nephrologist, was interviewed by news anchor Lisa Hart of Fox 2 NOW AM to discuss prevention and early detection of kidney disease in honor of World Kidney Day on March 9, 2017. World Kidney Day, a joint initiative of the International Society of Nephrology and the International Federation of Kidney Foundations, […]
March Madness … Kidney Style! NephMadness 2017 Brackets Announced
Hit the bench, US college basketball! Nephrology has its own March Madness – NephMadness 2017 – courtesy of the crew at AJKD Blog, the official blog of the American Journal of Kidney Diseases. Since 2013, this month-long educational tournament plays out across all social media outlets, providing good-natured competition while highlighting the latest advances and […]
Fellows ÓhAinmhire, Kadyrov and Koolwal Win Research Day Awards
We are proud to announce that the top three awards of the 2017 Midwest Nephrology Fellows’ Research Day conference went to Eoghainin ÓhAinmhire PhD, Farid Kadyrov, BS, and Pooja Koolwal, MD, of the Division of Nephrology at Washington University. Nephrology fellows from institutions across the region met in Kansas City on February 17 for the […]